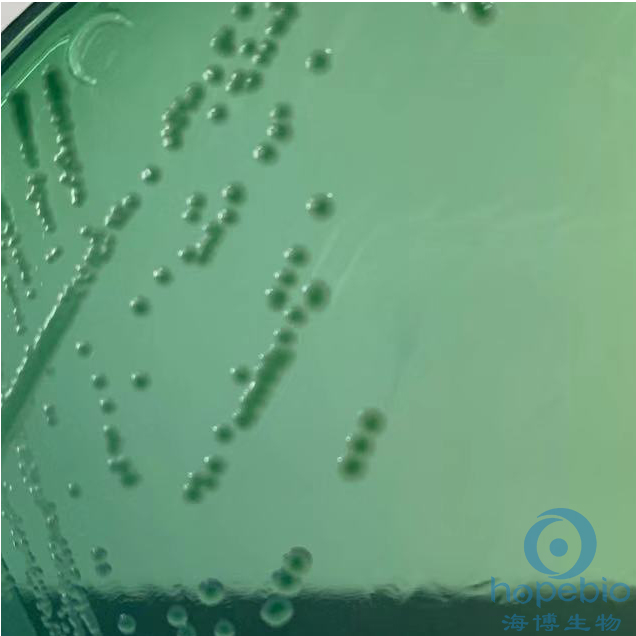
HE琼脂(GB4789.4-2024标准)
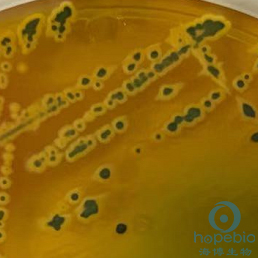
HE琼脂(GB4789.4-2024标准)

相关产品推荐更多 >
万千商家帮你免费找货
0 人在求购买到急需产品
- 详细信息
- 文献和实验
- 技术资料
- 库存:
999
- 英文名:
Hektoen Enteric Agar
- 保质期:
三年
- 供应商:
青岛海博生物
- 规格:
250g
用途:用于沙门氏菌选择性分离培养。
成分(g/L)
| 蛋白胨 | 12.0 |
| 牛肉浸粉 | 3.0 |
| 胆盐 | 20.0 |
| 乳糖 | 12.0 |
| 蔗糖 | 12.0 |
| 水杨苷 | 2.0 |
| 氯化钠 | 5.0 |
| 溴麝香草酚兰 | 0.064 |
| 硫代硫酸钠 | 6.8 |
| 柠檬酸铁铵 | 0.8 |
| 脱氧胆酸钠 | 2.0 |
| 酸性品红 | 0.1 |
| 琼脂 | 18.0 |
| pH值7.5±0.2 | 25℃ |
检验原理:
蛋白胨、牛肉浸粉在培养基中作为基础营养物质提供菌体细胞生长所需的氮源、碳源等;氯化钠维持体系渗透压平衡;胆盐主要抑制革兰氏阳性菌的生长;培养基中的蔗糖、水杨苷、乳糖作为鉴别系统;溴麝香草酚兰和酸性品红作为酸碱指示剂,能把发酵糖类和不发酵糖类的细菌区别开来,前者为橘黄色菌落,后者为淡蓝绿色菌落;柠檬酸铁铵及硫代硫酸钠分别做为产硫hua氢的指示剂和底物,能产硫hua氢但不发酵糖类的沙门氏菌的菌落边缘呈无色半透明,中心呈黑色。
用法:
称取本品93.77g,加热煮沸完全溶解于1000ml蒸馏水中,冷至48℃±2℃时,倾入无菌平皿,勿过度加热,勿高压灭菌。
不同细菌在HE琼脂平板上的生长特征:
![]() |
![]() |
![]() |
||
|
大肠埃希氏菌ATCC25922 无色菌落,无黑色中心 |
|
福氏志贺氏菌ATCC12022 蓝绿色菌落,无黑色中心 |
|
甲型副伤han沙门菌CMCC50093 蓝绿色菌落,无黑色中心 |
![]() |
![]() |
![]() |
||
|
普通变形杆菌ATCC13315 蓝绿色菌落,黑色中心 |
|
奇yi变形杆菌CMCC49005 蓝绿色菌落,黑色中心 |
|
鼠伤寒sha门氏菌ATCC14028 蓝绿色菌落,黑色中心 |
HE琼脂(GB4789.4-2024标准)微生物灵敏度试验:
按标签用法制备培养基,接种以下质控菌株,放置36±1℃需氧培养18-24小时。


风险提示:丁香通仅作为第三方平台,为商家信息发布提供平台空间。用户咨询产品时请注意保护个人信息及财产安全,合理判断,谨慎选购商品,商家和用户对交易行为负责。对于医疗器械类产品,请先查证核实企业经营资质和医疗器械产品注册证情况。
文献和实验成分 脙胨 12g 牛肉膏 3g 乳糖 12g 蔗糖 12g 水杨素 2g 胆盐 20g 氯化钠 5g 琼脂 18~20g 蒸馏水 1000mL 0.4%溴麝香草酚蓝溶液 16mL Andrade指示剂 20mL 甲液 20mL 乙
-。 5.3.6 必要时按表6进行沙门氏菌生化群的鉴别。 表6沙门氏菌属各生化群的鉴别 5.4 血清学分型鉴定 具体内容见GB/T4789.4-2003《食品卫生微生物学检验沙门氏菌检验》中6.4。 5.5 菌型的判定和结果报告 综合以上生化试验和血清学分型鉴定的结果,按照GB/T4789.4-2003《食品卫生微生物学检验沙门氏菌检验》中表8或有关沙门氏菌属抗原表判定菌型,并报告结果。 注:本文参照GB/T4789.4-2003《食品卫生微生物学检验沙门氏菌检验》
前处理,不但快速、高效,免除了很多繁琐的重复劳动,还可避免样品间的交叉污染,因此拍打均质作为样品处理标准方法写进国标“GB4789.2-2010 食品微生物检验 菌落总数测定”中。 以法国Interscience重量稀释器和拍打匀浆机为例,具体的操作如下: 自动稀释: 1、无菌样品袋采集样品,单独存放,避免交叉污染。 2、将开袋器Bagopen放在重量稀释器上(用于加入样品前打开袋口,避免用手开袋造成污染)。 3、在重量稀释器BabyGravimat上设定稀释倍数10,放上均质袋,重量清零,加入
技术资料暂无技术资料 索取技术资料